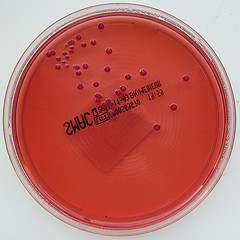
petri dish

Last month, the Health Department of Hawaii announced an E. coli outbreak and to date, the source of the food poisoning has not yet been identified. Epidemiologists at the agency have yet to find the link and are worried that the chances are growing dimmer with the passing of time.
The closing of investigations before the identification of the source has been established is however, not as uncommon as most may perceive. Michele Nakata, who works at the agency said that there have been a number of cases that have been left cold and for the more intricate outbreaks, such as the one experienced in Hawaii, the chances that the source will be identified are usually less than ten percent.
Investigators who worked on the outbreak had planned to identify the common grocery purchase among the victims, an endeavor that did not shed much light on the case. The investigations had begun in March and two months later there are more dead ends than they had hoped for. There are, however, many lessons to be learned about epidemiology in the country from this episode.
Nakata went on to say that successful completion of the investigation relies heavily on a number of factors, among them the species of the pathogen, the source of the outbreak and how many victims are affected. E. coli is a very complex pathogen and it usually takes a couple of days for the symptoms of an E. Coli infection to be displayed. Also, most people affected with the bacteria usually ignore the symptoms and only visit a doctor when the condition worsens. Moreover, the testing stage of the products is a whole other process in itself, especially when it involves many victims and numerous tests. Confirmation tests have to be done in order to identify the pathogen’s DNA fingerprint. Eventually an E. coli outbreak can be identified about two weeks after the infection has taken place.
She however, said that despite the challenges, the agency would continue to do their level best to handle outbreaks since they usually affect a number of people.

Leave a Reply